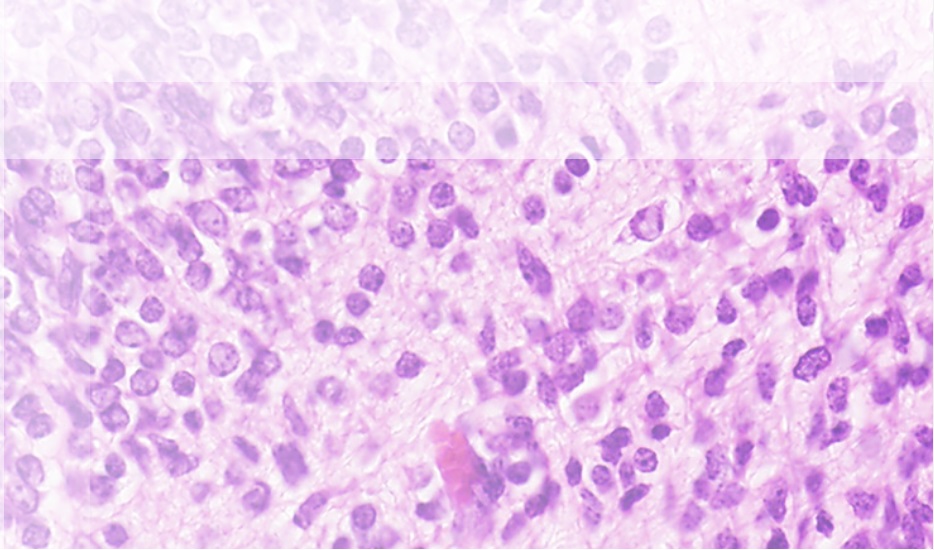
Epithelioid cell GIST stained by hematoxylin eosin

Collaborations
Collaborations
Tagline or Statement
Enter information about your collaborations. Remove default text. Excepteur sint occaecat cupidatat non proident, sunt in culpa qui officia deserunt mollit anim id est laborum.
Our Collaborators
Enter some information about your collaborators. Lorem ipsum dolor sit amet, consectetur adipiscing elit, sed do eiusmod tempor incididunt ut labore et dolore magna aliqua. Ut sem viverra aliquet eget sit amet tellus. Elementum tempus egestas sed sed risus pretium. In hac habitasse platea dictumst vestibulum rhoncus est pellentesque elit.
![]()
![]()
![]()
![]()
![]()
![]()
![]()
![]()